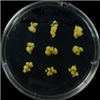

Korean Collection for Type Cultures
KCTC provides the distribution services
Find Resources
KCTC PC4127
| KCTC No. | PC4127 |
|---|---|
| KCTC No. (old) | PC10417 |
| LMO | false |
| Resource Type | plant cell line |
| Family Name | Umbelliferae |
| Name | Ledebouriella seseloides |
| Korean Name | 방풍 |
| Plant Cell Powder | |
| Synonym | |
| History | 김석원 |
| Other Collection No. | BP1421616 |
| Source | Leaf |
| Products | |
| Application | |
| Temperature | 25 ℃ |
| KCTC Media No. |
KCTC media No. 1312 MS1D |
| Culture Morphology | Callus |
| Embryo Genic | |
| Light Require | Dark |
| ABTS Activity (90%) | |
| DPPH Activity (90%) | |
| SOD Activity (90%) | |
| Images |
|
| Price | ₩ 100000 |
| MTA Restrictions | Only NON-COMMERCIAL USE for reference strains and/or academic researches |
If you use the resources sold by our KCTC for papers or patents, please make sure to write the phrase "The biological resources used in this research were distributed from KCTC"




